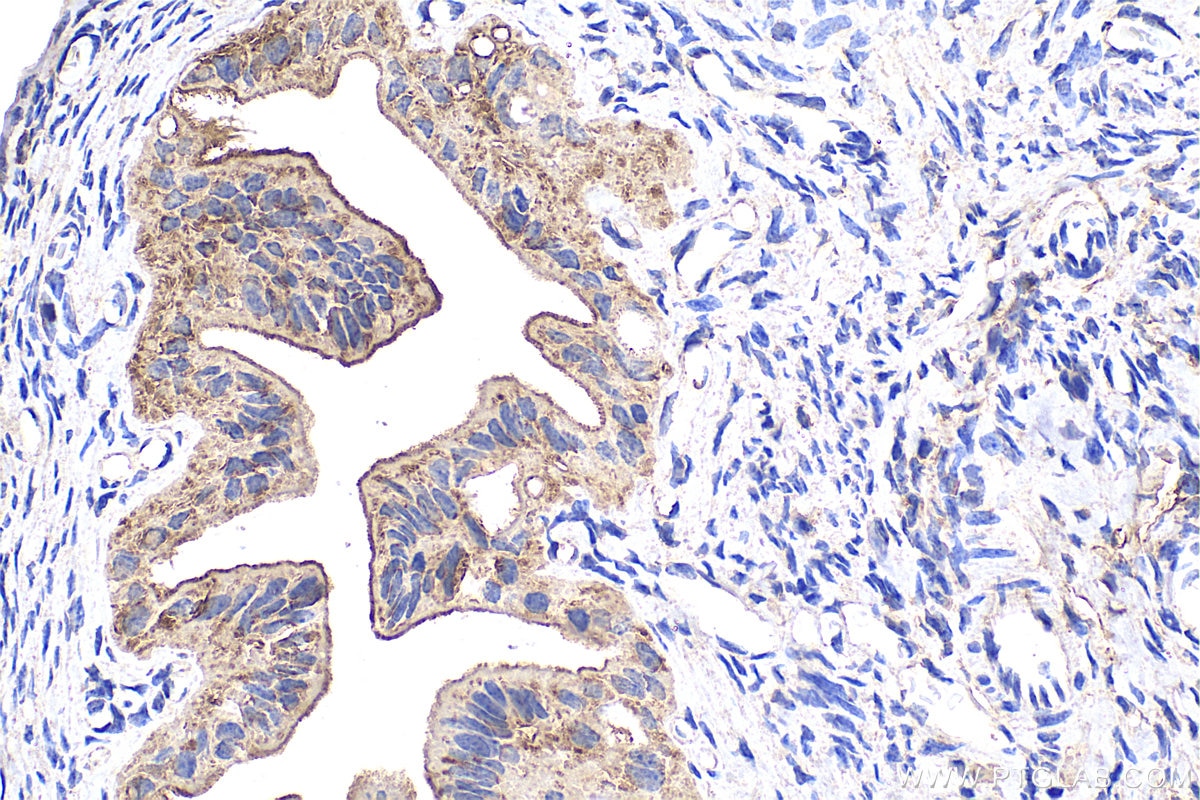

Tested Applications
| Positive WB detected in | HeLa cells, HEK-293T cells, human brain tissue, human heart tissue, human liver tissue, L02 cells, HepG2 cells, Jurkat cells, human placenta tissue, NIH/3T3 cells, rat liver tissue |
| Positive IP detected in | HEK-293T cells, mouse liver tissue, rat liver tissue |
| Positive IHC detected in | mouse liver tissue, mouse ovary tissue Note: suggested antigen retrieval with TE buffer pH 9.0; (*) Alternatively, antigen retrieval may be performed with citrate buffer pH 6.0 |
| Positive IF/ICC detected in | MCF-7 cells, A431 cells |
| Positive FC (Intra) detected in | MCF-7 cells |
Recommended dilution
| Application | Dilution |
|---|---|
| Western Blot (WB) | WB : 1:5000-1:50000 |
| Immunoprecipitation (IP) | IP : 0.5-4.0 ug for 1.0-3.0 mg of total protein lysate |
| Immunohistochemistry (IHC) | IHC : 1:50-1:500 |
| Immunofluorescence (IF)/ICC | IF/ICC : 1:200-1:800 |
| Flow Cytometry (FC) (INTRA) | FC (INTRA) : 0.40 ug per 10^6 cells in a 100 µl suspension |
| It is recommended that this reagent should be titrated in each testing system to obtain optimal results. | |
| Sample-dependent, Check data in validation data gallery. | |
Published Applications
| KD/KO | See 1 publications below |
| WB | See 11 publications below |
| IHC | See 2 publications below |
| IF | See 2 publications below |
Product Information
10345-1-AP targets RNH1 in WB, IHC, IF/ICC, FC (Intra), IP, ELISA applications and shows reactivity with human, mouse, rat samples.
| Tested Reactivity | human, mouse, rat |
| Cited Reactivity | human, mouse |
| Host / Isotype | Rabbit / IgG |
| Class | Polyclonal |
| Type | Antibody |
| Immunogen |
CatNo: Ag0350 Product name: Recombinant human RNH1 protein Source: e coli.-derived, PGEX-4T Tag: GST Domain: 1-214 aa of BC000677 Sequence: MSLDIQSLDIQCEELSDARWAELLPLLQQCQVVRLDDCGLTEARCKDISSALRVNPALAELNLRSNELGDVGVHCVLQGLQTPSCKIQKLSLQNCCLTGAGCGVLSSTLRTLPTLQELHLSDNLLGDAGLQLLCEGLLDPQCRLEKLQLEYCSLSAASCEPLASVLRAKPDFKELTVSNNDINEAGVHVLCQGLKDSPCQLEALKLESCGVTSD Predict reactive species |
| Full Name | ribonuclease/angiogenin inhibitor 1 |
| Calculated Molecular Weight | 50 kDa |
| Observed Molecular Weight | 45-50 kDa |
| GenBank Accession Number | BC000677 |
| Gene Symbol | RNH1 |
| Gene ID (NCBI) | 6050 |
| RRID | AB_2269733 |
| Conjugate | Unconjugated |
| Form | Liquid |
| Purification Method | Antigen affinity purification |
| UNIPROT ID | P13489 |
| Storage Buffer | PBS with 0.02% sodium azide and 50% glycerol, pH 7.3. |
| Storage Conditions | Store at -20°C. Stable for one year after shipment. Aliquoting is unnecessary for -20oC storage. 20ul sizes contain 0.1% BSA. |
Background Information
Ribonuclease/ angiogenin inhibitor (RNH, synonyms: RAI, MGC4569, MGC18200, MGC54054) is a protein that binds tightly to ribonucleases in cells and may be essential in the control of mRNA degradation and gene expression. The human RNH gene has been regionally localized to chromosome band 11p15 by in situ hybridization.
Protocols
| Product Specific Protocols | |
|---|---|
| FC protocol for RNH1 antibody 10345-1-AP | Download protocol |
| IF protocol for RNH1 antibody 10345-1-AP | Download protocol |
| IHC protocol for RNH1 antibody 10345-1-AP | Download protocol |
| IP protocol for RNH1 antibody 10345-1-AP | Download protocol |
| WB protocol for RNH1 antibody 10345-1-AP | Download protocol |
| Standard Protocols | |
|---|---|
| Click here to view our Standard Protocols |
Publications
| Species | Application | Title |
|---|---|---|
EMBO J Myeloid cells protect intestinal epithelial barrier integrity through the angiogenin/plexin-B2 axis. | ||
J Cell Biol Angiogenin cleaves tRNA and promotes stress-induced translational repression.
| ||
Proc Natl Acad Sci U S A Sex hormone-dependent tRNA halves enhance cell proliferation in breast and prostate cancers. | ||
J Proteome Res Post-translational modifications and protein-specific isoforms in endometriosis revealed by 2D DIGE. | ||
J Biol Chem Genome-wide identification and quantitative analysis of cleaved tRNA fragments induced by cellular stress. |